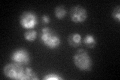
YBR207W
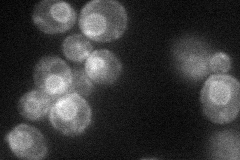
YBR207W
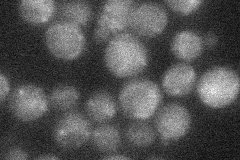
YBR207W
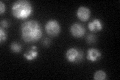
YBR207W

View description
Putative high affinity iron transporter involved in transport of intravacuolar stores of iron; forms complex with Fet5p; expression is regulated by iron; proposed to play indirect role in endocytosis
Localization:
Intensity:
Fold change:
Significance:
-
C’ GFP library in SD
vacuole membrane56.13 -
N' NOP1pr-GFP in SD
ER36.415 -
N' TEF2pr-mCherry in SD

ER11.3517 -
N' NATIVEpr-GFP in SD
below threshold18.7828 -
N' TEF2pr-VC and Cyto-VN in SD

below threshold25.8722 -
C’ GFP library in SD+DTT

vacuole membrane65.61.16No -
C’ GFP library in SD+H2O2

vacuole membrane54.990.97No -
C’ GFP library in Starvation Media
vacuole membrane66.491.18No -
C’ GFP library on the background of Pup2-DaMP

vacuole membrane -
C’ GFP library on the background of CCT mutant

vacuole membrane48.96830.872253No
